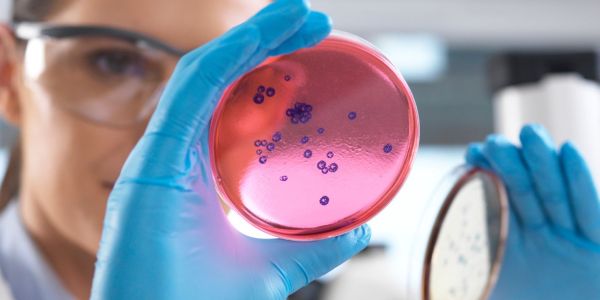

Verloskundig
Centrum
Bergweg
Rotterdam
Centrum
Bergweg
Rotterdam
Bij Verloskundig Centrum Bergweg, jouw verloskundige in
Rotterdam, staan het welzijn en de gezondheid van je baby en jou centraal. We bieden eerlijke, persoonlijke zorg, afgestemd op jouw wensen. Onze meerwaarde? Een klein team met veel ervaring!